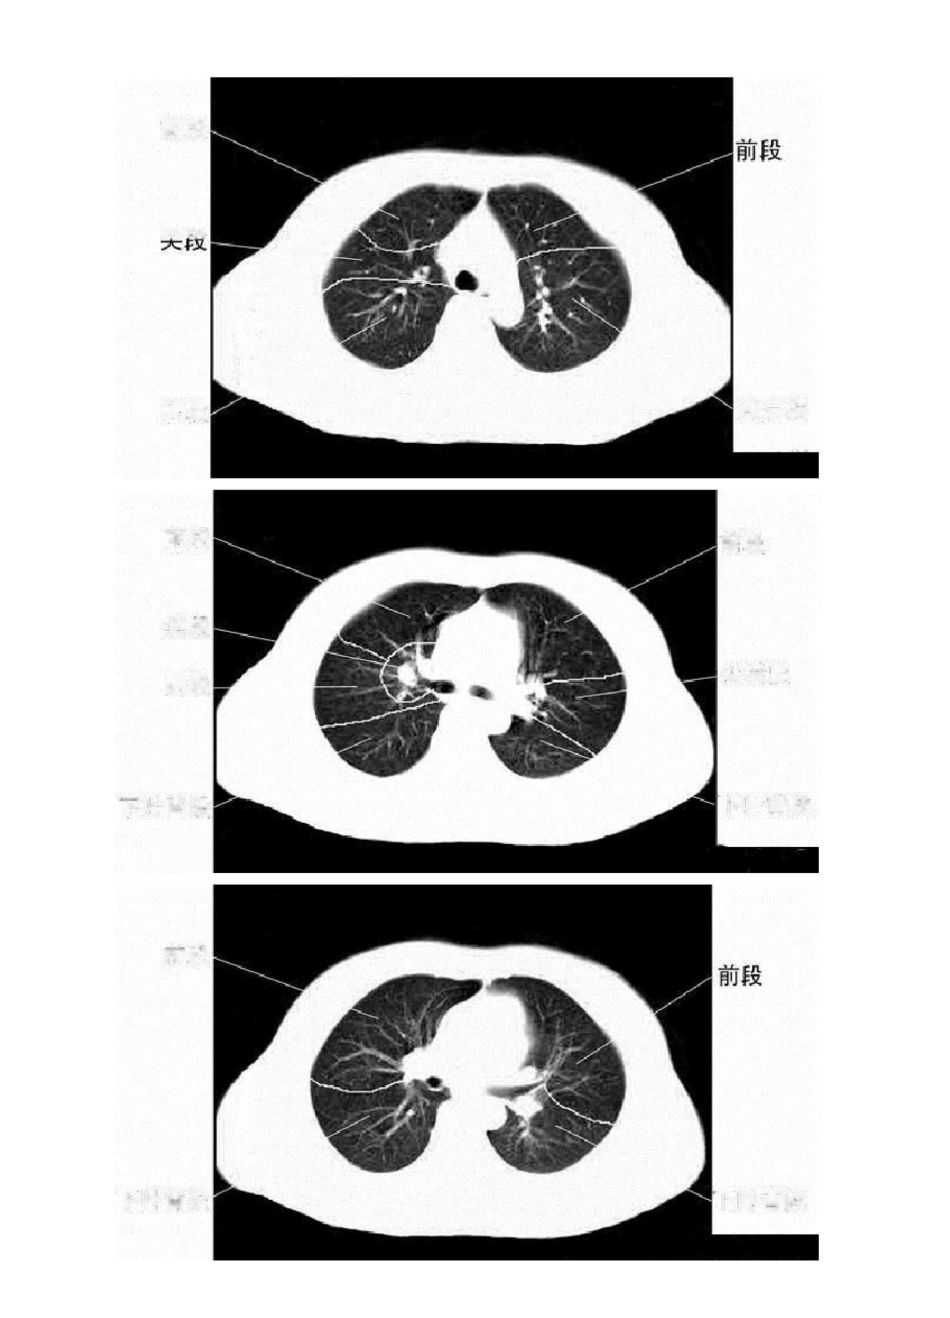

胸部 CT 肺段划分口诀独眼能看双上肺,左下还留一点背
对眼能看前后背,双眼能看前和背
嵴角出现能看中舌背,基底干出现就看余下肺
“独眼能看双上肺,左下还留一点背”:指气管层面,能显示两上肺,在偏下方层面,能看到左肺下叶背段“对眼能看前后背”:在支气管分叉层面(T4 以下)能看到两肺上叶前、后段及两肺下叶背段"双眼能看前和背":双眼与对眼都是指左右主支气管,“对眼”指左右主支气管距离近,"两眼"是气管分叉下方层面及肺动脉层面,左右支气管距离较远,此时断面图像上只能显示上叶前段和下叶背段"嵴角出现能看中舌背":嵴角指有中叶支气管与下叶支气管的夹角,内有右上肺静脉的断面,此层面能看到右肺中叶,左上肺舌叶及两肺下叶背段“基底干出现就看余下肺”:两下叶支气管分出基底段时能观察中叶,舌叶及两肺下叶各基底段,所以觉得此句应改为“基底干出现就看中舌余下肺”图解如下:前段i\xrn
尖后段后段前段前段尖段尖后段后段下叶背段下叶背段前段下叶昔段下叶背段內侧段夕卜侧段前基底段外基底段后基底段内基底段下叶背段下叶背段前段前段上舌段外侧段前基底段外基底段后基底段内侧段下舌段内前基底段外基底段右肺上叶右侧斜裂右肺下叶背段左肺上叶左侧斜裂左肺下叶背段右肺中叶右侧斜裂右肺下叶左肺上叶舌段左侧斜裂左肺下叶右肺上叶水平裂少血管带'右肺下叶左侧斜裂少血管带右肺上叶水平裂少血管带右侧斜裂右肺下叶左肺上叶左侧斜裂少血管带水平裂顶部右侧斜裂左主支气管右上叶尖段支气營右上叶支气管右上叶肺静脉后支左上叶尖后段支气管右主支气管 _ 左主支气管左肺动脉右主支气管支气營右下肺动脉干中间段支气管左肺上静脉左上叶舌毀支气管右肺中时动脉右中叶支气管右下肺动脉右下支气管咅下支气管左下肺动脉前内基底支左下肺动脉后外基底支左肺下静脉后右下叶内基底脱支气管右下肺动脉右下叶支气管右肺下静脉左肺下静脉左下肺内前基底段动脉左下叶内前基底駁支气管